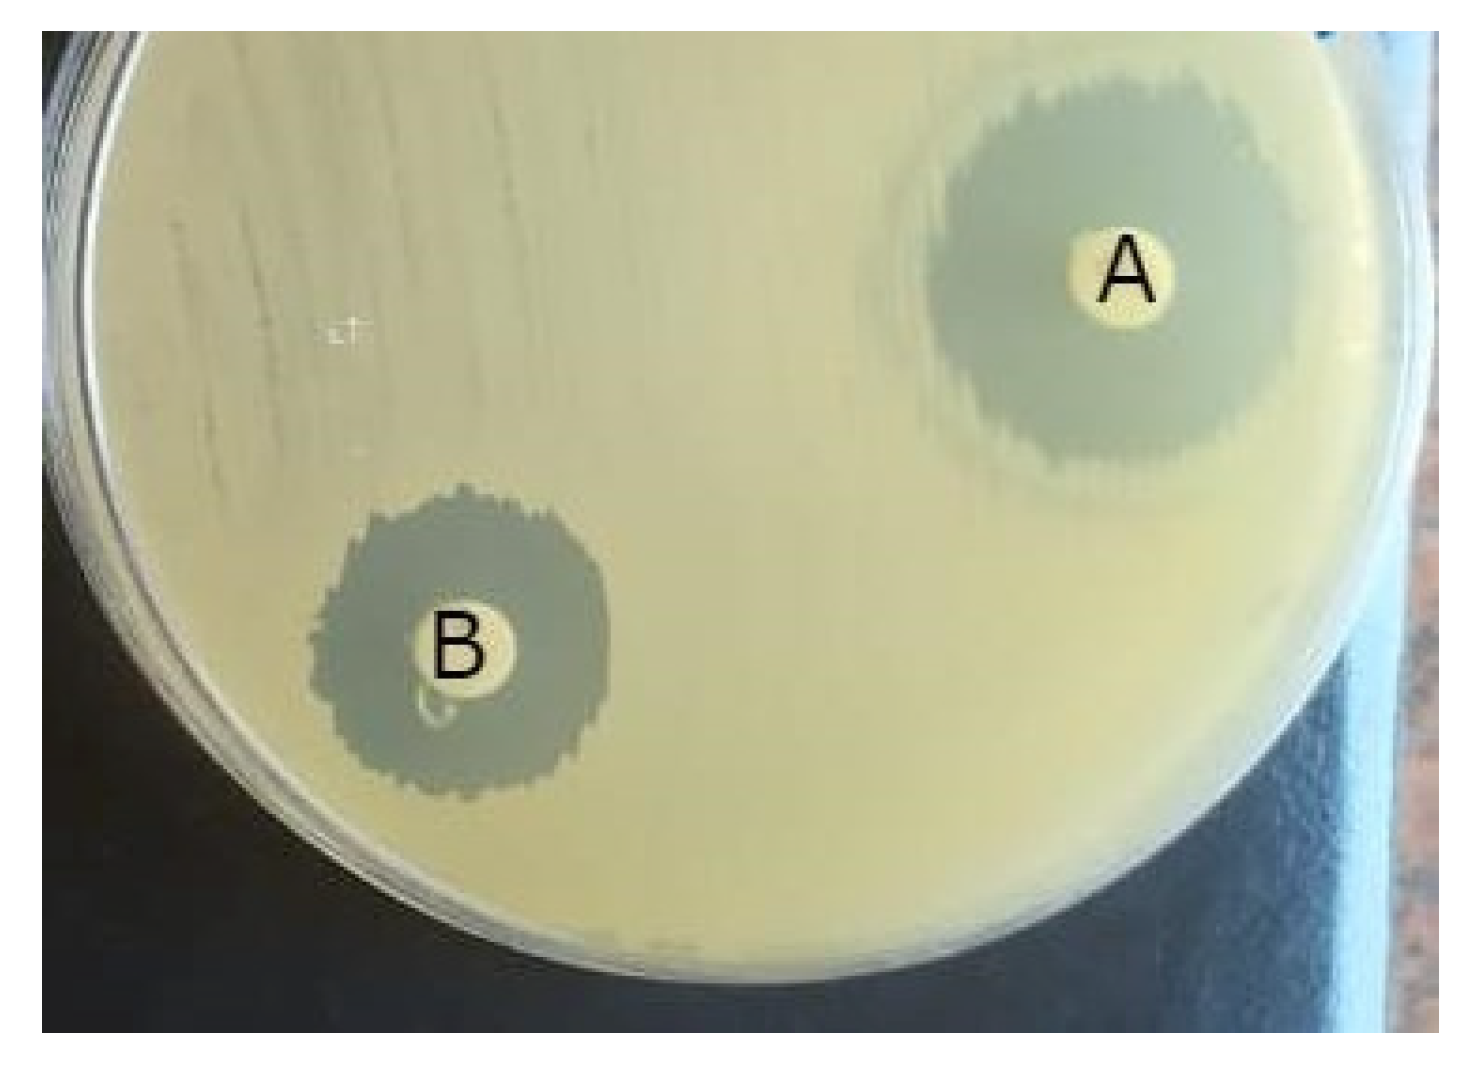

Fungal Secondary Metabolites/Dicationic Pyridinium Iodide Combinations in Combat against Multi-Drug Resistant Microorganisms
Abstract
1. Introduction
2. Results and Discussions
2.1. Molecular Identification of Fungal Isolates
2.2. Antibacterial Activity of Fungal Bioactive Secondary Metabolites
2.3. GC-MS Analysis of Fungal Secondary Metabolites
2.4. Molecular Docking Study
2.5. Comparative Study between T. lixii, A. niger Crude Extracts and Dicationic Pyridinium Iodide Compound
2.5.1. Disc Diffusion Technique
2.5.2. Checkerboard Dilution Technique
2.6. Mechanistic Action of the Combined Formula
3. Materials and Methods
3.1. Tested Pathogens
3.2. Endophytic Fungal Isolation
3.3. Molecular Identification of the Fungal Isolates
3.4. Seed Culture Preparations and Extraction of Fungal Secondary Metabolites
3.5. Antibacterial Activity of Fungal Secondary Metabolites
3.6. GC-MS Analysis of Fungal Secondary Metabolites
3.7. Chemical Synthesis of Dicationic Pyridinium Iodide Compounds
3.7.1. Characterization of the Prepared Dicationic Pyridinium Iodide (3)
3.7.2. Molecular Docking
Database Generation and Optimization
3.8. Combination Study between the Fungal Extracts and the Synthesized Dicationic Pyridinium Iodide Compound
3.9. Antibacterial Mechanism of Action of the Combined Formulae
3.9.1. Transmission Electron Microscopic (TEM) Examination of the Treated Microbial Cells
3.9.2. Time-Kill Curve
3.9.3. Reactive Oxygen Species (ROS) Study
4. Conclusions
Supplementary Materials
Author Contributions
Funding
Institutional Review Board Statement
Informed Consent Statement
Data Availability Statement
Acknowledgments
Conflicts of Interest
Sample Availability
References
- Peyclit, L.; Yousfi, H.; Rolain, J.M.; Bittar, F. Drug repurposing in medical mycology: Identification of compounds as potential antifungals to overcome the emergence of multidrug-resistant fungi. Pharmaceuticals 2021, 14, 488. [Google Scholar]
- Miryala, S.K.; Anbarasu, A.; Ramaiah, S. Role of SHV-11, a class a β-lactamase, gene in multidrug resistance among Klebsiella pneumoniae strains and understanding its mechanism by gene network analysis. Microb. Drug Resist. 2020, 26, 900–908. [Google Scholar] [PubMed]
- Kandasamy, G.D.; Kathirvel, P. Insights into bacterial endophytic diversity and isolation with a focus on their potential applications—A review. Microbiol. Res. 2022, 266, 127256. [Google Scholar] [PubMed]
- Du, W.; Yao, Z.; Li, J.; Sun, C.; Xia, J.; Wang, B.; Shi, D.; Ren, L. Diversity and antimicrobial activity of endophytic fungi isolated from Securinega suffruticosa in the Yellow River Delta. PLoS ONE 2020, 15, e0229589. [Google Scholar]
- Nischitha, R.; Shivanna, M.B. Antimicrobial activity and metabolite profiling of endophytic fungi in Digitaria bicornis (Lam) Roem. and Schult. and Paspalidium flavidum (Retz.) A. Camus. 3 Biotech 2021, 11, 53. [Google Scholar]
- Mao, Z.; Zhang, W.; Wu, C.; Feng, H.; Peng, Y.; Shahid, H.; Cui, Z.; Ding, P.; Shan, T. Diversity and antibacterial activity of fungal endophytes from Eucalyptus exserta. BMC Microbiol. 2021, 21, 155. [Google Scholar]
- Śliżewska, W.; Struszczyk-Świta, K.; Marchut-Mikołajczyk, O. Metabolic Potential of Halophilic Filamentous Fungi—Current Perspective. Int. J. Mol. Sci. 2022, 23, 4189. [Google Scholar] [PubMed]
- Torres, A.B.; Bedoya, K.V.; Guerra, J.D.; Montoya-Estrada, C.N.; Castro-Ríos, K. Ultraviolet radiation and generally recognized as safe (GRAS) preservatives for inactivation of Aspergillus niger in vitro and corn dough. Braz. J. Food Technol. 2022, 25, 1–8. [Google Scholar] [CrossRef]
- Devi, R.; Kaur, T.; Guleria, G.; Rana, K.L.; Kour, D.; Yadav, N.; Yadav, A.N.; Saxena, A.K. Fungal secondary metabolites and their biotechnological applications for human health. In New and Future Developments in Microbial Biotechnology and Bioengineering; Elsevier: Amsterdam, The Netherlands, 2020; pp. 147–161. [Google Scholar]
- MacFarlane, D.R.; Kar, M.; Pringle, J.M. Fundamentals of Ionic Liquids: From Chemistry to Applications; John Wiley & Sons: Hoboken, NJ, USA, 2017. [Google Scholar]
- Zhuang, W.; Hachem, K.; Bokov, D.; Ansari, M.J.; Nakhjiri, A.T. Ionic liquids in pharmaceutical industry: A systematic review on applications and future perspectives. J. Mol. Liq. 2021, 349, 118145. [Google Scholar]
- Ali, I.; Nadeem Lone, M.; AAl-Othman, Z.; Al-Warthan, A.; Marsin Sanagi, M. Heterocyclic scaffolds: Centrality in anticancer drug development. Curr. Drug Targets 2015, 16, 711–734. [Google Scholar] [CrossRef]
- Verma, G.; Marella, A.; Shaquiquzzaman, M.; Akhtar, M.; Ali, M.R.; Alam, M.M. A review exploring biological activities of hydrazones. J. Pharm. Bioallied Sci. 2014, 6, 69. [Google Scholar] [PubMed]
- Bayrak, H.; Demirbas, A.; Demirbas, N.; Karaoglu, S.A. Synthesis of some new 1, 2, 4-triazoles starting from isonicotinic acid hydrazide and evaluation of their antimicrobial activities. Eur. J. Med. Chem. 2009, 44, 4362–4366. [Google Scholar] [PubMed]
- Rezki, N.; Al-Yahyawi, A.M.; Bardaweel, S.K.; Al-Blewi, F.F.; Aouad, M.R. Synthesis of novel 2,5-disubstituted-1,3,4-thiadiazoles clubbed 1,2,4-triazole, 1,3,4-thiadiazole, 1,3,4-oxadiazole and/or Schiff base as potential antimicrobial and antiproliferative agents. Molecules 2015, 20, 16048–16067. [Google Scholar]
- Abdelgawad, M.A.; Labib, M.B.; Abdel-Latif, M. Pyrazole-hydrazone derivatives as anti-inflammatory agents: Design, synthesis, biological evaluation, COX-1, 2/5-LOX inhibition and docking study. Bioorganic Chem. 2017, 74, 212–220. [Google Scholar]
- Moustafa, G.; Khalaf, H.; Naglah, A.; Al-Wasidi, A.; Al-Jafshar, N.; Awad, H. Synthesis, molecular docking studies, in vitro antimicrobial and antifungal activities of novel dipeptide derivatives based on N-(2-(2-hydrazinyl-2-oxoethylamino)-2-oxoethyl)-nicotinamide. Molecules 2018, 23, 761. [Google Scholar]
- Oliveira, P.F.; Guidetti, B.; Chamayou, A.; André-Barrès, C.; Madacki, J.; Korduláková, J.; Mori, G.; Silvia Orena, B.; Chiarelli, L.R.; Pasca, M.R.; et al. Mechanochemical synthesis and biological evaluation of novel isoniazid derivatives with potent antitubercular activity. Molecules 2017, 22, 1457. [Google Scholar] [PubMed]
- Rezki, N.; Al-Sodies, S.A.; Ahmed, H.E.; Ihmaid, S.; Messali, M.; Ahmed, S.; Aouad, M.R. A novel dicationic ionic liquids encompassing pyridinium hydrazone-phenoxy conjugates as antimicrobial agents targeting diverse high resistant microbial strains. J. Mol. Liq. 2019, 284, 431–444. [Google Scholar]
- Quang, T.H.; Phong, N.V.; Anh, L.N.; Hanh, T.T.H.; Cuong, N.X.; Ngan, N.T.T.; Minh, C.V. Secondary metabolites from a peanut-associated fungus Aspergillus niger IMBC-NMTP01 with cytotoxic, anti-inflammatory, and antimicrobial activities. Nat. Prod. Res. 2022, 36, 1215–1223. [Google Scholar] [PubMed]
- Padhi, S.; Masi, M.; Panda, S.K.; Luyten, W.; Cimmino, A.; Tayung, K.; Evidente, A. Antimicrobial secondary metabolites of an endolichenic Aspergillus niger isolated from lichen thallus of Parmotrema ravum. Nat. Prod. Res. 2020, 34, 2573–2580. [Google Scholar]
- Chigozie, V.U.; Okezie, M.U.; Ajaegbu, E.E.; Okoye, F.B.; Esimone, C.O. Bioactivities and HPLC analysis of secondary metabolites of a morphologically identified endophytic Aspergillus fungus isolated from Mangifera indica. Nat. Prod. Res. 2021, 36, 5884–5888. [Google Scholar]
- Venice, F.; Davolos, D.; Spina, F.; Poli, A.; Prigione, V.P.; Varese, G.C.; Ghignone, S. Genome sequence of Trichoderma lixii MUT3171, a promising strain for mycoremediation of PAH-contaminated sites. Microorganisms 2020, 8, 1258. [Google Scholar] [CrossRef]
- Aires-de-Sousa, M.; Lopes, E.; Gonçalves, M.L.; Pereira, A.L.; Machado e Costa, A.; de Lencastre, H.; Poirel, L. Intestinal carriage of extended-spectrum beta-lactamase–producing Enterobacteriaceae at admission in a Portuguese hospital. Eur. J. Clin. Microbiol. Infect. Dis. 2020, 39, 783–790. [Google Scholar] [CrossRef] [PubMed]
- Carvalho, I.; Chenouf, N.S.; Carvalho, J.A.; Castro, A.P.; Silva, V.; Capita, R.; Alonso-Calleja, C.; Enes Dapkevicius, M.D.L.N.; Igrejas, G.; Torres, C.; et al. Multidrug-resistant Klebsiella pneumoniae harboring extended spectrum β-lactamase encoding genes isolated from human septicemias. PLoS ONE 2021, 16, e0250525. [Google Scholar] [CrossRef] [PubMed]
- Guo, K.; Zhang, Q.; Zhao, J.; Li, Z.; Ran, J.; Xiao, Y.; Zhang, S.; Hu, M. Antibacterial mechanism of Aspergillus niger xj spore powder crude extract B10 against Agrobacterium tumefaciens T-37. Biotechnol. Biotechnol. Equip. 2021, 35, 162–169. [Google Scholar] [CrossRef]
- Qiao, Y.; Zhang, X.; He, Y.; Sun, W.; Feng, W.; Liu, J.; Hu, Z.; Xu, Q.; Zhu, H.; Zhang, J.; et al. Aspermerodione, a novel fungal metabolite with an unusual 2, 6-dioxabicyclo [2.2. 1] heptane skeleton, as an inhibitor of penicillin-binding protein 2a. Sci. Rep. 2018, 8, 5454. [Google Scholar] [CrossRef]
- Verma, A.; Gupta, P.; Rai, N.; Tiwari, R.K.; Kumar, A.; Salvi, P.; Kamble, S.C.; Kumar Singh, S.; Gautam, V. Assessment of biological activities of fungal endophytes derived bioactive compounds Isolated from Amoora rohituka. J. Fungi 2022, 8, 285. [Google Scholar] [CrossRef] [PubMed]
- Clinical and Laboratory Standards Institute. Performance Standards for Antimicrobial Susceptibility Testing. CLSI Supplement M100. 2017. Available online: https://clsi.org/media/1795/catalog2017_web.pdf (accessed on 1 January 2018).
- Diab, S.E.; Tayea, N.A.; Elwakil, B.H.; Gad, A.A.E.M.; Ghareeb, D.A.; Olama, Z.A. Novel Amoxicillin-Loaded Sericin Biopolymeric Nanoparticles: Synthesis, Optimization, Antibacterial and Wound Healing Activities. Int. J. Mol. Sci. 2022, 23, 11654. [Google Scholar] [CrossRef]
- Elnaggar, Y.S.; Elwakil, B.H.; Elshewemi, S.S.; El-Naggar, M.Y.; Bekhit, A.A.; Olama, Z.A. Novel Siwa propolis and colistinintegrated chitosan nanoparticles: Elaboration; in vitro and in vivo appraisal. Nanomedicine 2020, 15, 1269–1284. [Google Scholar] [CrossRef]
- Aljohani, F.S.; Hamed, M.T.; Bakr, B.A.; Shahin, Y.H.; Abu-Serie, M.M.; Awaad, A.K.; El-Kady, H.; Elwakil, B.H. In vivo bio-distribution and acute toxicity evaluation of greenly synthesized ultra-small gold nanoparticles with different biological activities. Sci. Rep. 2022, 12, 6269. [Google Scholar] [CrossRef]
- Elnahas, R.A.; Elwakil, B.H.; Elshewemi, S.S.; Olama, Z.A. Egyptian Olea europaea leaves bioactive extract: Antibacterial and wound healing activity in normal and diabetic rats. J. Tradit. Complement. Med. 2021, 11, 427–434. [Google Scholar] [CrossRef]
- Shaaban, M.M.; Ragab, H.M.; Akaji, K.; McGeary, R.P.; Bekhit, A.E.A.; Hussein, W.M.; Kurz, J.L.; Elwakil, B.H.; Bekhit, S.A.; Ibrahim, T.M.; et al. Design, synthesis, biological evaluation and in silico studies of certain aryl sulfonyl hydrazones conjugated with 1, 3-diaryl pyrazoles as potent metallo-β-lactamase inhibitors. Bioorganic Chem. 2020, 105, 104386. [Google Scholar] [CrossRef] [PubMed]
- Al-Humaidi, J.Y.; Shaaban, M.M.; Rezki, N.; Aouad, M.R.; Zakaria, M.; Jaremko, M.; Hagar, M.; Elwakil, B.H. 1, 2, 3-Triazole-Benzofused Molecular Conjugates as Potential Antiviral Agents against SARS-CoV-2 Virus Variants. Life 2022, 12, 1341. [Google Scholar] [CrossRef]
- White, R.L.; Burgess, D.S.; Manduru, M.; Bosso, J.A. Comparison of three different in vitro methods of detecting synergy: Time-kill, checkerboard, and E test. Antimicrob. Agents Chemother. 1996, 40, 1914–1918. [Google Scholar] [CrossRef] [PubMed]
- Wang, D.; Xue, B.; Wang, L.; Zhang, Y.; Liu, L.; Zhou, Y. Fungus-mediated green synthesis of nano-silver using Aspergillus sydowii and its antifungal/antiproliferative activities. Scientific Reports 2021, 11, 10356. [Google Scholar] [CrossRef]
- Almotairy, A.R.Z.; Amer, A.M.; El-Kady, H.; Elwakil, B.H.; El-Khatib, M.; Eldrieny, A.M. Nanostructured γ-Al2O3 Synthesis Using an Arc Discharge Method and its Application as an Antibacterial Agent against XDR Bacteria. Inorganics 2023, 11, 42. [Google Scholar] [CrossRef]
- Bhuvaneshwari, M.; Bairoliya, S.; Parashar, A.; Chandrasekaran, N.; Mukherjee, A. Differential toxicity of Al2O3 particles on Gram-positive and Gram-negative sediment bacterial isolates from freshwater. Environ. Sci. Pollut. Res. 2016, 23, 12095–12106. [Google Scholar] [CrossRef]

| Tested Pathogens | T. lixii Crude Extract | A. niger Crude Extract | ||||
|---|---|---|---|---|---|---|
| IZ Diameter (mm) | MIC (µg/mL) | MBC (µg/mL) | IZ Diameter (mm) | MIC (µg/mL) | MBC (µg/mL) | |
| Pseudomonas aeruginosa | 14.5 | 250 | 500 | 19.0 | 250 | 500 |
| Acinetobacter baumannii | 9.0 | 500 | 1000 | 7.5 | 500 | 1000 |
| Proteus vulgaris | 12.5 | 250 | 500 | 13.0 | 250 | 500 |
| Staphylococcus aureus | 11.0 | 500 | 1000 | 21.0 | 250 | 1000 |
| Escherichia coli | 20.0 | 250 | 250 | 12.0 | 250 | 250 |
| Klebsiella aerogenes | 8.0 | 500 | 1000 | 7.5 | 1000 | 1000 |
| Klebsiella pneumoniae | 16.0 | 250 | 500 | 11.0 | 250 | 500 |
| Strain | RT | Compound | Area% |
|---|---|---|---|
| A. niger | 7.29 | 1-Octanol, 2,7-dimethyl | 6.72 |
| 19.15 | 2-(Octadecyloxy)ethanol | 3.00 | |
| 12.74 | Pentadecanoic acid, 14-methyl-, methyl ester | 26.66 | |
| 14.17 | 9-Octadecenoic acid (Z)-, methyl ester | 18.01 | |
| T. lixii | 7.49 | 2,4-Decadienal, (E,E) | 10.69 |
| 13.36 | Undecanoic acid | 7.98 | |
| 14.59 | 9-Octadecenoic acid (Z)-, methyl ester | 10.32 | |
| 16.65 | 1,2-15,16-Diepoxyhexadecane | 7.84 | |
| 18.42 | Heptadecane, 9hexyl | 1.86 |
| Compounds | Docking Score (kcal/mol) | 2D Binding Mode within SHV-1 Active Site | |
|---|---|---|---|
| Ref. | Co-crystallized ligand LN1-255 | −6.44 | ![]() |
| Syn. Comp. | Dicationic pyridinium iodide compound | −6.38 | ![]() |
| A. niger | 1-Octanol, 2,7-dimethyl | −5.00 | ![]() |
| 2-(Octadecyloxy)ethanol | −6.40 | ![]() | |
| Pentadecanoic acid, 14-methyl-, methyl ester | −6.51 | ![]() | |
| 9-Octadecenoic acid (Z)-, methyl ester | −6.50 | ![]() | |
| T. lixii | 2,4-Decadienal, (E,E) | −5.04 | ![]() |
| Undecanoic acid | −5.62 | ![]() | |
| 9-Octadecenoic acid (Z)-, methyl ester | −6.96 | ![]() | |
| 1,2-15,16-Diepoxyhexadecane | −6.56 | ![]() | |
| Heptadecane, 9hexyl | −6.99 | ![]() |
| Tested Pathogens | IZ Diameter (mm) | ||||
|---|---|---|---|---|---|
| Dicationic Pyridinium Iodide | A. niger Crude Extract | T. lixii Crude Extract | A. niger Crude Extract + Dicationic Pyridinium Iodide | T. lixii Crude Extract + Dicationic Pyridinium Iodide | |
| P. aeruginosa | 10.0 | 19.0 | 14.5 | 30.5 | 14.5 |
| A. baumannii | 9.0 | 7.5 | 9.0 | 17.0 | 9.0 |
| P. vulgaris | 10.5 | 13.0 | 12.5 | 24.5 | 12.5 |
| S. aureus | 14.3 | 21.0 | 11.0 | 22.0 | 16.0 |
| E. coli | 13.0 | 12.0 | 20.0 | 34.5 | 20.0 |
| K. aerogenes | 14.0 | 7.5 | 8.0 | 23.0 | 8.0 |
| K. pneumoniae | 12.0 | 11.0 | 16.0 | 24.5 | 32.0 |
| Antibacterial Agent | MIC of Single Drug (µg/mL) | MIC of Combined Drug (µg/mL) | FIC | FICI | Interpretation | |
|---|---|---|---|---|---|---|
| K. pneumoniae | dicationic pyridinium iodide | 250.0 | 50.0 | 0.20 | - | - |
| A. niger crude extract | 250.0 | 37.5 | 0.15 | 0.35 | Synergy | |
| T. lixii crude extract | 250.0 | 50.0 | 0.20 | 0.4 | Synergy | |
Disclaimer/Publisher’s Note: The statements, opinions and data contained in all publications are solely those of the individual author(s) and contributor(s) and not of MDPI and/or the editor(s). MDPI and/or the editor(s) disclaim responsibility for any injury to people or property resulting from any ideas, methods, instructions or products referred to in the content. |
© 2023 by the authors. Licensee MDPI, Basel, Switzerland. This article is an open access article distributed under the terms and conditions of the Creative Commons Attribution (CC BY) license (https://creativecommons.org/licenses/by/4.0/).
Share and Cite
Abdelalatif, A.M.; Elwakil, B.H.; Mohamed, M.Z.; Hagar, M.; Olama, Z.A. Fungal Secondary Metabolites/Dicationic Pyridinium Iodide Combinations in Combat against Multi-Drug Resistant Microorganisms. Molecules 2023, 28, 2434. https://doi.org/10.3390/molecules28062434
Abdelalatif AM, Elwakil BH, Mohamed MZ, Hagar M, Olama ZA. Fungal Secondary Metabolites/Dicationic Pyridinium Iodide Combinations in Combat against Multi-Drug Resistant Microorganisms. Molecules. 2023; 28(6):2434. https://doi.org/10.3390/molecules28062434
Chicago/Turabian StyleAbdelalatif, Ayoub M., Bassma H. Elwakil, Mohamed Zakaria Mohamed, Mohamed Hagar, and Zakia A. Olama. 2023. "Fungal Secondary Metabolites/Dicationic Pyridinium Iodide Combinations in Combat against Multi-Drug Resistant Microorganisms" Molecules 28, no. 6: 2434. https://doi.org/10.3390/molecules28062434
APA StyleAbdelalatif, A. M., Elwakil, B. H., Mohamed, M. Z., Hagar, M., & Olama, Z. A. (2023). Fungal Secondary Metabolites/Dicationic Pyridinium Iodide Combinations in Combat against Multi-Drug Resistant Microorganisms. Molecules, 28(6), 2434. https://doi.org/10.3390/molecules28062434












